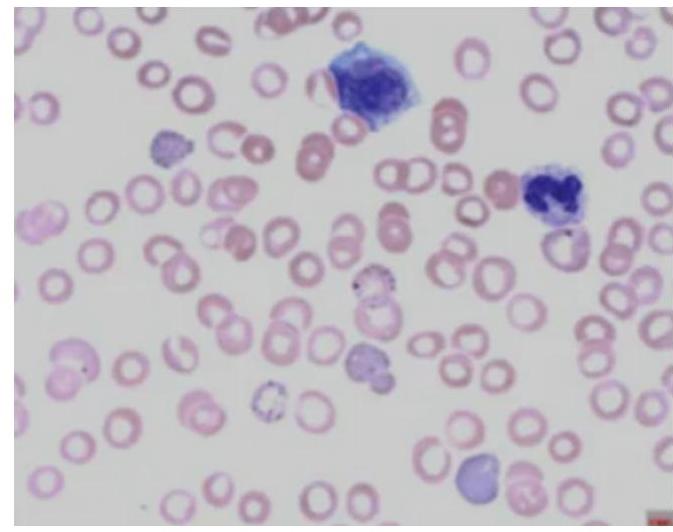
Image for question 5

Buon's line is seen in: Al 07; Rajasthan 11; NEET 13; JIPMER 13
Pink disease is seen in
A patient presents with complaints of hair loss and behavioral changes noted by his wife. Upon examination, the doctor observes a loss of eyebrows. After further assessment, including an examination of the nails, what type of poisoning is suspected in this case?
A farmer presented with confusion, increased salivation, fasciculations, miosis, tachycardia and hypertension. Poison that can cause these manifestations:
Which of the following diagnoses give the hematological picture as given below?
Which of the following substances is a toxin but has also been historically used as a therapeutic emetic in poisoning management?
Arsenic poisoning presents with symptoms mimicking which condition?
Improper handling of mercury in the clinic results in occupational hazard through:
The most common toxin causing dilated cardiomyopathy is
Gastric lavage is contraindicated in the following:
Get full access to all questions, explanations, and performance tracking.
Scan to download app